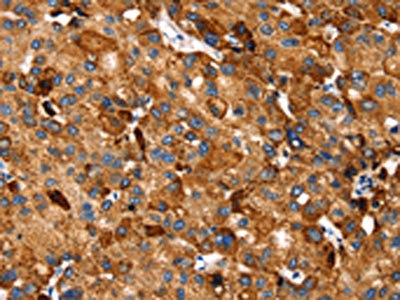

SLC27A5 Antibody
-
中文名稱:SLC27A5兔多克隆抗體
-
貨號:CSB-PA218953
-
規格:¥1100
-
圖片:
-
The image on the left is immunohistochemistry of paraffin-embedded Human liver cancer tissue using CSB-PA218953(SLC27A5 Antibody) at dilution 1/20, on the right is treated with synthetic peptide. (Original magnification: ×200)
-
The image on the left is immunohistochemistry of paraffin-embedded Human lung cancer tissue using CSB-PA218953(SLC27A5 Antibody) at dilution 1/20, on the right is treated with synthetic peptide. (Original magnification: ×200)
-
Gel: 6%SDS-PAGE, Lysate: 40 μg, Lane: Mouse liver tissue, Primary antibody: CSB-PA218953(SLC27A5 Antibody) at dilution 1/250, Secondary antibody: Goat anti rabbit IgG at 1/8000 dilution, Exposure time: 2 minutes
-
-
其他:
產品詳情
-
Uniprot No.:
-
基因名:
-
別名:ACSB antibody; ACSVL6 antibody; BA CoA ligase antibody; BA-CoA ligase antibody; BACS antibody; BAL antibody; Bile acid CoA ligase antibody; Bile acid-CoA ligase antibody; Bile acyl CoA synthetase antibody; Bile acyl-CoA synthetase antibody; Cholate CoA ligase antibody; Cholate--CoA ligase antibody; FACVL3 antibody; FATP 5 antibody; FATP-5 antibody; FATP5 antibody; Fatty acid Coenzyme A ligase very long chain 3 antibody; Fatty acid transport protein 5 antibody; Fatty-acid-coenzyme A ligase antibody; FLJ22987 antibody; S27A5_HUMAN antibody; Slc27a5 antibody; Solute carrier family 27 (fatty acid transporter) member 5 antibody; Solute carrier family 27 member 5 antibody; Very long chain acyl CoA synthetase homolog 2 antibody; Very long chain acyl CoA synthetase related protein antibody; very long-chain 3 antibody; Very long-chain acyl-CoA synthetase homolog 2 antibody; Very long-chain acyl-CoA synthetase-related protein antibody; VLACS related antibody; VLACS-related antibody; VLACSR antibody; VLCS H2 antibody; VLCS-H2 antibody; VLCSH2 antibody
-
宿主:Rabbit
-
反應種屬:Human,Mouse
-
免疫原:Synthetic peptide of Human SLC27A5
-
免疫原種屬:Homo sapiens (Human)
-
標記方式:Non-conjugated
-
抗體亞型:IgG
-
純化方式:Antigen affinity purification
-
濃度:It differs from different batches. Please contact us to confirm it.
-
保存緩沖液:-20°C, pH7.4 PBS, 0.05% NaN3, 40% Glycerol
-
產品提供形式:Liquid
-
應用范圍:ELISA,WB,IHC
-
推薦稀釋比:
Application Recommended Dilution ELISA 1:1000-1:2000 WB 1:200-1:1000 IHC 1:25-1:100 -
Protocols:
-
儲存條件:Upon receipt, store at -20°C or -80°C. Avoid repeated freeze.
-
貨期:Basically, we can dispatch the products out in 1-3 working days after receiving your orders. Delivery time maybe differs from different purchasing way or location, please kindly consult your local distributors for specific delivery time.
-
用途:For Research Use Only. Not for use in diagnostic or therapeutic procedures.
相關產品
靶點詳情
-
功能:Acyl-CoA synthetase that catalyzes the activation of bile acids via formation of bile acid CoA thioesters which is necessary for their subsequent conjugation with glycine or taurine. Both primary bile acids (cholic acid and chenodeoxycholic acid) and secondary bile acids (deoxycholic acid and lithocholic acid) are the principal substrates. Also exhibits acyl CoA synthetase activity that activates very long-chain fatty acids (VLCFAs) by catalyzing the formation of fatty acyl-CoA. In vitro, also activates 3-alpha,7-alpha,12-alpha-trihydroxy-5-beta-cholestanate (THCA), the C27 precursor of cholic acid deriving from the de novo synthesis from cholesterol. Exhibits long-chain fatty acids (LCFA) transport activity. Plays an important role in hepatic fatty acid uptake and bile acid reconjugation and recycling but not in de novo synthesis of bile acids.
-
基因功能參考文獻:
- Based on a study of 10 pediatric patients, genetic defects that disrupt bile acid amidation cause fat-soluble vitamin deficiency and growth failure, indicating the importance of bile acid conjugation in lipid absorption. PMID: 23415802
- Bile acid-CoA ligase deficiency is a new inborn error of bile acid metabolism [case report] PMID: 22089923
- A promoter polymorphism in the FATP5 is associated with the metabolic syndrome and steatosis. PMID: 20945272
-
亞細胞定位:Endoplasmic reticulum membrane; Multi-pass membrane protein. Microsome. Cell membrane; Multi-pass membrane protein.
-
蛋白家族:ATP-dependent AMP-binding enzyme family
-
組織特異性:Predominantly expressed in liver.
-
數據庫鏈接:
Most popular with customers
-
-
YWHAB Recombinant Monoclonal Antibody
Applications: ELISA, WB, IHC, IF, FC
Species Reactivity: Human, Mouse, Rat
-
Phospho-YAP1 (S127) Recombinant Monoclonal Antibody
Applications: ELISA, WB, IHC
Species Reactivity: Human
-
-
-
-
-